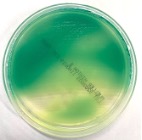

この記事では好気性グラム陰性桿菌 , 微好気性グラム陰性らせん菌とスピロヘータ科 , グラム陰性球菌 ( 双球菌 ) , Mycoplasma科 , Rickettsia科・Chlamydia科 , 嫌気性菌 , 抗酸菌の菌種別の解説をします。
菌種別まとめ①の続きです!

大きな差はないですが、問題数は緑膿菌 , らせん菌 , 抗酸菌が多かったです!
らせん菌は関連疾患も含めてしっかり押さえておきましょう!
大枠の項目数はこの記事の方が多いですが、出てくる菌種数は菌種別まとめ①のほうが多い…
逆に言うとこの記事に出てくる項目の菌は割と決まった菌種ばかりを問う問題が多いということです。
好気性グラム陰性桿菌
好気性グラム陰性桿菌で覚えるべき細菌は ① Pseudomonas aeruginosa ② Acinetobacter baumannii ③ Stenotrophomonas maltophilia ④ Legionella pneumophila である.

この項目では、特にワタシのことを覚えて下さい!
Pseudomonas aeruginosa , Acinetobacter baumannii , Stenotrophomonas maltophiliaはブドウ糖非発酵菌に分類され , これらは腸内細菌科の細菌とは逆にブドウ糖を嫌気的に発酵しない. ブドウ糖非発酵菌は全体的に環境中に存在する菌が多く , 薬剤に対する抵抗性が高く , MDRP ( 多剤耐性緑膿菌 ) やMDRA ( 多剤耐性アシネトバクター ) ※ などの多剤耐性菌も存在する.
ブドウ糖非発酵菌はPseudomonas aeruginosa ( 出題頻度が高い ) とAcinetobacter baumanniiについて覚えておけばよい. 下記に示す“ブドウ糖非発酵グラム陰性桿菌はどれか”というような問題に関しては , 学生からすれば聞いたことがないような細菌名が並んでいるように感じるかもしれないが , 消去法で腸内細菌科の細菌を除外すれば正答に辿り着ける. したがって , 無数にあるブドウ糖非発酵菌すべてを抑える必要はなく , ブドウ糖非発酵菌の代表であるPseudomonas aeruginosaとAcinetobacter baumanniiをしっかり押さえておけばよい.
※ MDRPとMDRA等の薬剤耐性菌ついてはこの記事では詳しい解説はしない
第48回PM問63
ブドウ糖非発酵グラム陰性桿菌はどれか. 3つ選べ.
- Acinetobacter calcoaceticus ○
- Serratia marcescens → 腸内細菌科細菌
- Klebsiella pneumoniae → 腸内細菌科細菌
- Stenotrophomonas maltophilia ○
- Burkholderia cepacia ○
① Pseudomonas aeruginosa ( 緑膿菌 )
表 Pseudomonas aeruginosaの特徴的な性状
| 酸素要求性 | 偏性好気性 |
| 産生する色素 | ピオシアニン・ピオベルジンなど |
| 産生する酵素 | オキシダーゼ・アシルアミダーゼ |
| 運動性 ( 鞭毛の有無 ) | + ( 極単毛=一端に1本 ) |
| 発育温度 | 37℃・42℃でも発育可能 |
| 抗菌薬 | イミペネムなどのカルバペネム系やアミカシンなどのアミノグリコシド系に感性 |
② Acinetobacter baumannii

表 Acinetobacter baumanniiの特徴的な性状
| 酸素要求性 | 偏性好気性 |
| 運動性 ( 鞭毛の有無 ) | - |
| オキシダーゼテスト | - |
③ Stenotrophomonas maltophilia
オキシダーゼテストが陰性の環境中に存在する菌であり , 易感染宿主に肺炎を起こすことがあるが , 国家試験での出題は少ないため細かい性状については覚える必要はない.
④ Legionella pneumophila

微好気性グラム陰性らせん菌とスピロヘータ科
グラム陰性らせん菌に関する問題で主に出題されているのは① Campylobacter属と② Helicobacter属である. これらの共通性状として微好気条件 ( 3~15%の酸素環境 ) での発育 , オキシダーゼ試験とカタラーゼ試験が陽性であることが挙げられる.
スピロヘータ科もらせん形であるため , ここで解説するが , 第48回と第49回に1問出題されているのみであるため , スピロヘータ科に関しては余裕があれば目を通す程度でよい.
① Campylobacter属

表 Campylobacter jejuniの特徴的な性状
| 酸素要求性 | 微好気性 |
| 運動性 ( 鞭毛の有無 ) | + ( 単極または両極に1本 ) |
| 関連疾患 | Guillain-Barré症候群 |
| 選択培地 | Skirrow寒天培地 |
| 発育温度 | 42℃でも発育可能 |
② Helicobacter属

表 Helicobacter pyloriの特徴的な性状
| 酸素要求性 | 微好気性 |
| 主に産生する酵素 | ウレアーゼ ( 尿素分解テスト+ ) |
| 運動性 ( 鞭毛の有無 ) | + ( 単極に数本 ) |
| 関連疾患 | 胃癌・特発性血小板減少性紫斑病など |
| 抗菌薬 | ナリジクス酸:耐性 / セファロチン:感性 |
| 検査方法 | 分離培養・尿素呼気試験・糞便中抗原検査・血中 / 尿中抗体価測定法 組織染色による菌体の証明 |
③ スピロヘータ科 / レプトスピラ科
スピロヘータ科とレプトスピラ科はどちらもコイル状のグラム陰性桿菌である.
スピロヘータ科に関して問う問題は20年以上前に出題されているのみである. スピロヘータ科が原因となる感染症に , 梅毒 , 回帰熱 , ライム病などがある.
レプトスピラ科の分離培地としてコルトフ ( Korthof ) 培地 ( バイアル瓶に入った特殊な培地 ) がある. 薬剤感受性はスピロヘータ , レプトスピラどちらもペニシリンとテトラサイクリンなどに感性である.
グラム陰性球菌 ( 双球菌 )
グラム陰性球菌で覚えておくべき細菌はNeisseria gonorrhoeae ( 淋菌 ) , Neisseria meningitidis ( 髄膜炎菌 ) , Moraxella catarrhalisである. これらはそれぞれ検出される材料が異なるため , 画像問題では材料からどの菌種か推定できる.

表 Neisseria属とMoraxella属の特徴的な性状
| Neisseria gonorrhoeae | Neisseria meningitides | Moraxella catarrhalis | |
| 頻出材料 | 尿道分泌物 | 髄液 | 喀痰などの呼吸器材料 |
| オキシダーゼ | + | + | + |
| カタラーゼ | + | + | + |
| グルコース | + | + | - |
| マルトース | - | + | - |
| 感染症法 | 5類 ( 定点 ) | 無菌材料から検出されたとき 5類( 全数 ) | 該当なし |
Mycoplasma科
Mycoplasma科にはMycoplasma属とUreaplasma属があるが国家試験ではMycoplasma属のみの出題である.
Rickettsia科・Chlamydia科
Rickettsia科とChlamydia科は偏性細胞内寄生性 ( 生きた細胞内でのみ増殖できる ) である点など共通する項目が多く , 偏性細胞内寄生性である点はウイルスとも共通する.
表 主なRickettsia科の特徴的な性状
| Orientia tsutsugamushi ※ | Rickettsia prowazekii | Rickettsia rickettsii | Rickettsia japonica | |
| グラム染色性 | ||||
| 細胞寄生性 | ||||
| 核酸 | ||||
| 二分裂増殖 | ||||
| 薬剤感受性 | ||||
| 関連疾患 | ツツガムシ病 | 発疹チフス | ロッキー山紅斑熱 | 日本紅斑熱 |
| 媒介動物 | ダニ ( ツツガムシ ) | コロモジラミ | マダニ | マダニ |
※ Orientia tsutsugamushiは以前はRickettsia科Rickettsia属であったが現在はRickettsia科Orientia属である
表 主なChlamydia科とウイルスの比較
| Chlamydia trachomatis | Chlamydia psittaci | Chlamydia pneumoniae | ウイルス | |
| グラム染色性 | グラム陰性球菌状 | - | ||
| 細胞寄生性 | 偏性細胞寄生性 | 偏性細胞寄生性 | ||
| 核酸 | DNA・RNA | DNAまたはRNA | ||
| 二分裂増殖 | する | しない | ||
| 薬剤感受性 | マクロライド系抗菌薬 ( アジスロマイシン ) が第一選択となる | 抗生物質はすべて無効 | ||
| 関連疾患 | 性器クラミジア | オウム病 | 肺炎クラミジア | 種により様々 |
嫌気性菌

嫌気性菌の出題はClostridium属 ( グラム陽性桿菌 ) , Clostridioides difficile ( グラム陽性桿菌 ) ※・Bacteroides fragilis ( グラム陰性桿菌 ) が多い.
※ 旧名Clostridium difficileは2016年の名称変更によりClostridioides difficileとなり、新しいClostridioides属となった ( 臨床検査技師国家試験でも2021年施行の第67回からこの菌名で出題されている )
表 これまでに出題された嫌気性菌の特徴
| Clostridioides difficile | Clostridium属 | Bacteroides属 | Prevotella属 |
| ・グラム陽性桿菌 ・芽胞を形成する ・抗菌薬の長期投与で発症する偽膜性大腸炎の原因となる | ・グラム陽性 ( 大型 ) 桿菌 ・芽胞を形成する ・運動性+( ほとんどのClostridium属は運動性+であるがC.perfringensは- ) ・C.perfringensなど一部はレシチナーゼ陽性 | ・グラム陰性桿菌 ・BBE寒天培地に発育する( 胆汁耐性 ) ・エスクリンを加水分解する ・カタラーゼ陽性 ・ B.thetaiotaomicronはインドール陽性である | ・グラム陰性桿菌 ・BBE寒天培地に発育できない( 胆汁感受性 ) ・エスクリンを加水分解する ( P.biviaは陰性 ) ・一部のPrevotella 属( P.intermediaなど ) は黒色色素を産生する |
抗酸菌:Mycobacterium属

表 国家試験でよく問われるMycobacterium属の特徴
| Runyonの分類 | 培養温度 | 特徴 | ||
| 遅発育菌 | 結核菌群 | M.tuberculosis ( 結核菌 ) | 37℃ | ・R型コロニー形成 ・ナイアシンテスト陽性 ・アルカリに抵抗性がある ・細胞内寄生性 ( マクロファージ内で増殖可能 ) ・インターフェロンγ遊離試験が診断に有用 |
| M.bovis ( ウシ型結核菌 ) | ・BCGワクチン株 ・M.tuberculosisとPCR検査で区別できない | |||
| Ⅰ群( 光発色菌 ) | M.marinum | 28℃ | 光照射後コロニーが黄色を呈する | |
| M.kansasii | 28℃・37℃ | |||
| Ⅱ群( 暗発色菌 ) | M.scrofulaceum / M.szulgai | 28℃・37℃ | 光に関係なくコロニーが橙色を呈する | |
| Ⅲ群( 非光発色菌 ) | M.avium / M.intracellulare | 28℃・37℃ | 非結核性抗酸菌症の原因菌 | |
| 迅速発育菌 | Ⅳ群 | M.fortuitum / M.abscessus | 28℃・37℃ | 7日以内にコロニーが肉眼で確認できる |
| M.leprae ( らい菌 ) | 培養不可 | ハンセン病の原因菌 | ||
おまけ

入院患者の喀痰です。
何がいるかわかりますか…?
…?

…?

答えはワタシデス!!バイオフィルム形成ちゅう♪
培養からはムコイド型の緑膿菌が検出されました。患者の気道内にバイオフィルムを形成した緑膿菌は粘性物質で菌体を包んで定着し、塗抹ではカエルの卵状に見え、培養ではM型集落が検出されます。
♦ ウラ解答の教材はこちら
♦ その他のまとめ記事はこちら
♦ 過去問周回サイトはこちら

